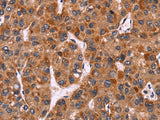
CARD11 Polyclonal Antibody Store at -20°C - MSE Supplies LLC

CARD11 Polyclonal Antibody Store at -20°C
SKU: E-AB-14822-200
CARD11 Polyclonal Antibody Store at -20°C
| SKU # | E-AB-14822 |
| Reactivity | Human, Mouse |
| Host | Rabbit |
| Applications | IHC |
Product Details
| Isotype | IgG |
| Host | Rabbit |
| Reactivity | Human, Mouse |
| Applications | IHC |
| Clonality | Polyclonal |
| Immunogen | Recombinant protein of human CARD11 |
| Abbre | CARD11 |
| Synonyms | 0610008L17Rik, 2410011D02Rik, BIMP 3, BIMP3, Bcl10 interacting maguk protein 3, CAR11, CARD 11, CARD containing MAGUK protein 3, CARD-containing MAGUK protein 1, CARD11, CARD11 protein, CARMA1, Card maguk protein 1, Carma 1, Caspase recruitment domain containing protei |
| Swissprot | |
| Cellular Localization | Cytoplasm. Membrane raft. Colocalized with DPP4 in membrane rafts. |
| Concentration | 0.3 mg/mL |
| Buffer | Phosphate buffered solution, pH 7.4, containing 0.05% stabilizer and 50% glycerol. |
| Purification Method | Affinity purification |
| Research Areas | Cancer, Cell Biology, Epigenetics and Nuclear Signaling, Immunology, Signal Transduction |
| Conjugation | Unconjugated |
| Storage | Store at -20°C Valid for 12 months. Avoid freeze / thaw cycles. |
| Shipping | The product is shipped with ice pack,upon receipt,store it immediately at the temperature recommended. |
Related Reagents
| Applications | Recommended Dilution |
| IHC | 1:50-1:200 |
Background
The protein encoded by this gene belongs to the membrane-associated guanylate kinase (MAGUK) family, a class of proteins that functions as molecular scaffolds for the assembly of multiprotein complexes at specialized regions of the plasma membrane.This protein is also a member of the CARD protein family, which is defined by carrying a characteristic caspase-associated recruitment domain (CARD).This protein has a domain structure similar to that of CARD14 protein.The CARD domains of both proteins have been shown to specifically interact with BCL10, a protein known to function as a positive regulator of cell apoptosis and NF-kappaB activation.